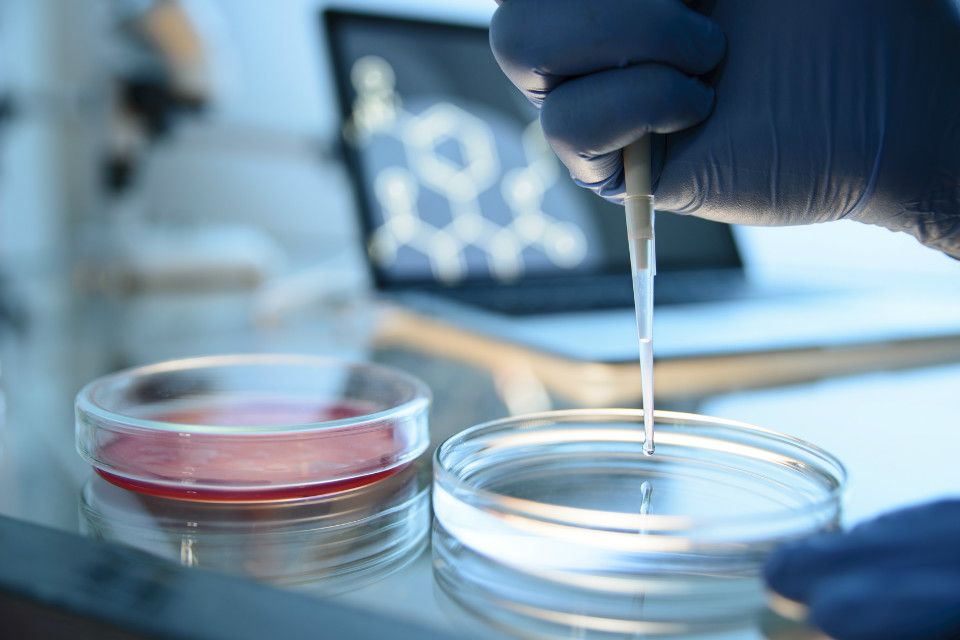
EUA: Cientistas avançam no uso células-tronco para doenças incuráveis

ÚLTIMAS
-
GEDEÃO NEGREIROS: Vereador solicita instalação de semáforo e faixa no Agenor de Carvalho
-
RONDONIENSE SÉRIE B: Primeira rodada da competição aconteceu nesta quinta (4)
-
Publicação Legal: ASSEMBLEIA GERAL ORDINÁRIA: SINDLIMPRO
-
Publicação Legal: ASSEMBLEIA GERAL EXTRAORDINÁRIA: FONTE AGUA MINERAL PARAÍSO S.A
-
CONEXÃO RONDONIAOVIVO: Escritora Tamara Ramos lança livro abordando o distúrbio bordeline
-
MULHER DE TENENTE: 'Chamei os colegas de farda pra fazer ele passar constrangimento'
-
Publicação Legal: AVISO DE LICITAÇÃO: CHAMAMENTO PÚBLICO Nº. 90406/2025/COESP/SUPEL/RO.
-
OURO PRETO: Artista Yves’s lança DVD ao vivo gravado no Bosque Municipal
-
Publicação Legal: AVISO DE LICITAÇÃO: PREGÃO ELETRÔNICO N.°: 90418/2025/SUPEL/RO
-
UPA EM NÚMEROS: Ferramenta mostra em tempo real o movimento das unidades de pronto atendimentos
Busca de Notícias - Você buscou por cura
© 2005 - 2025, Rondoniaovivo.com. Todos os direitos reservados